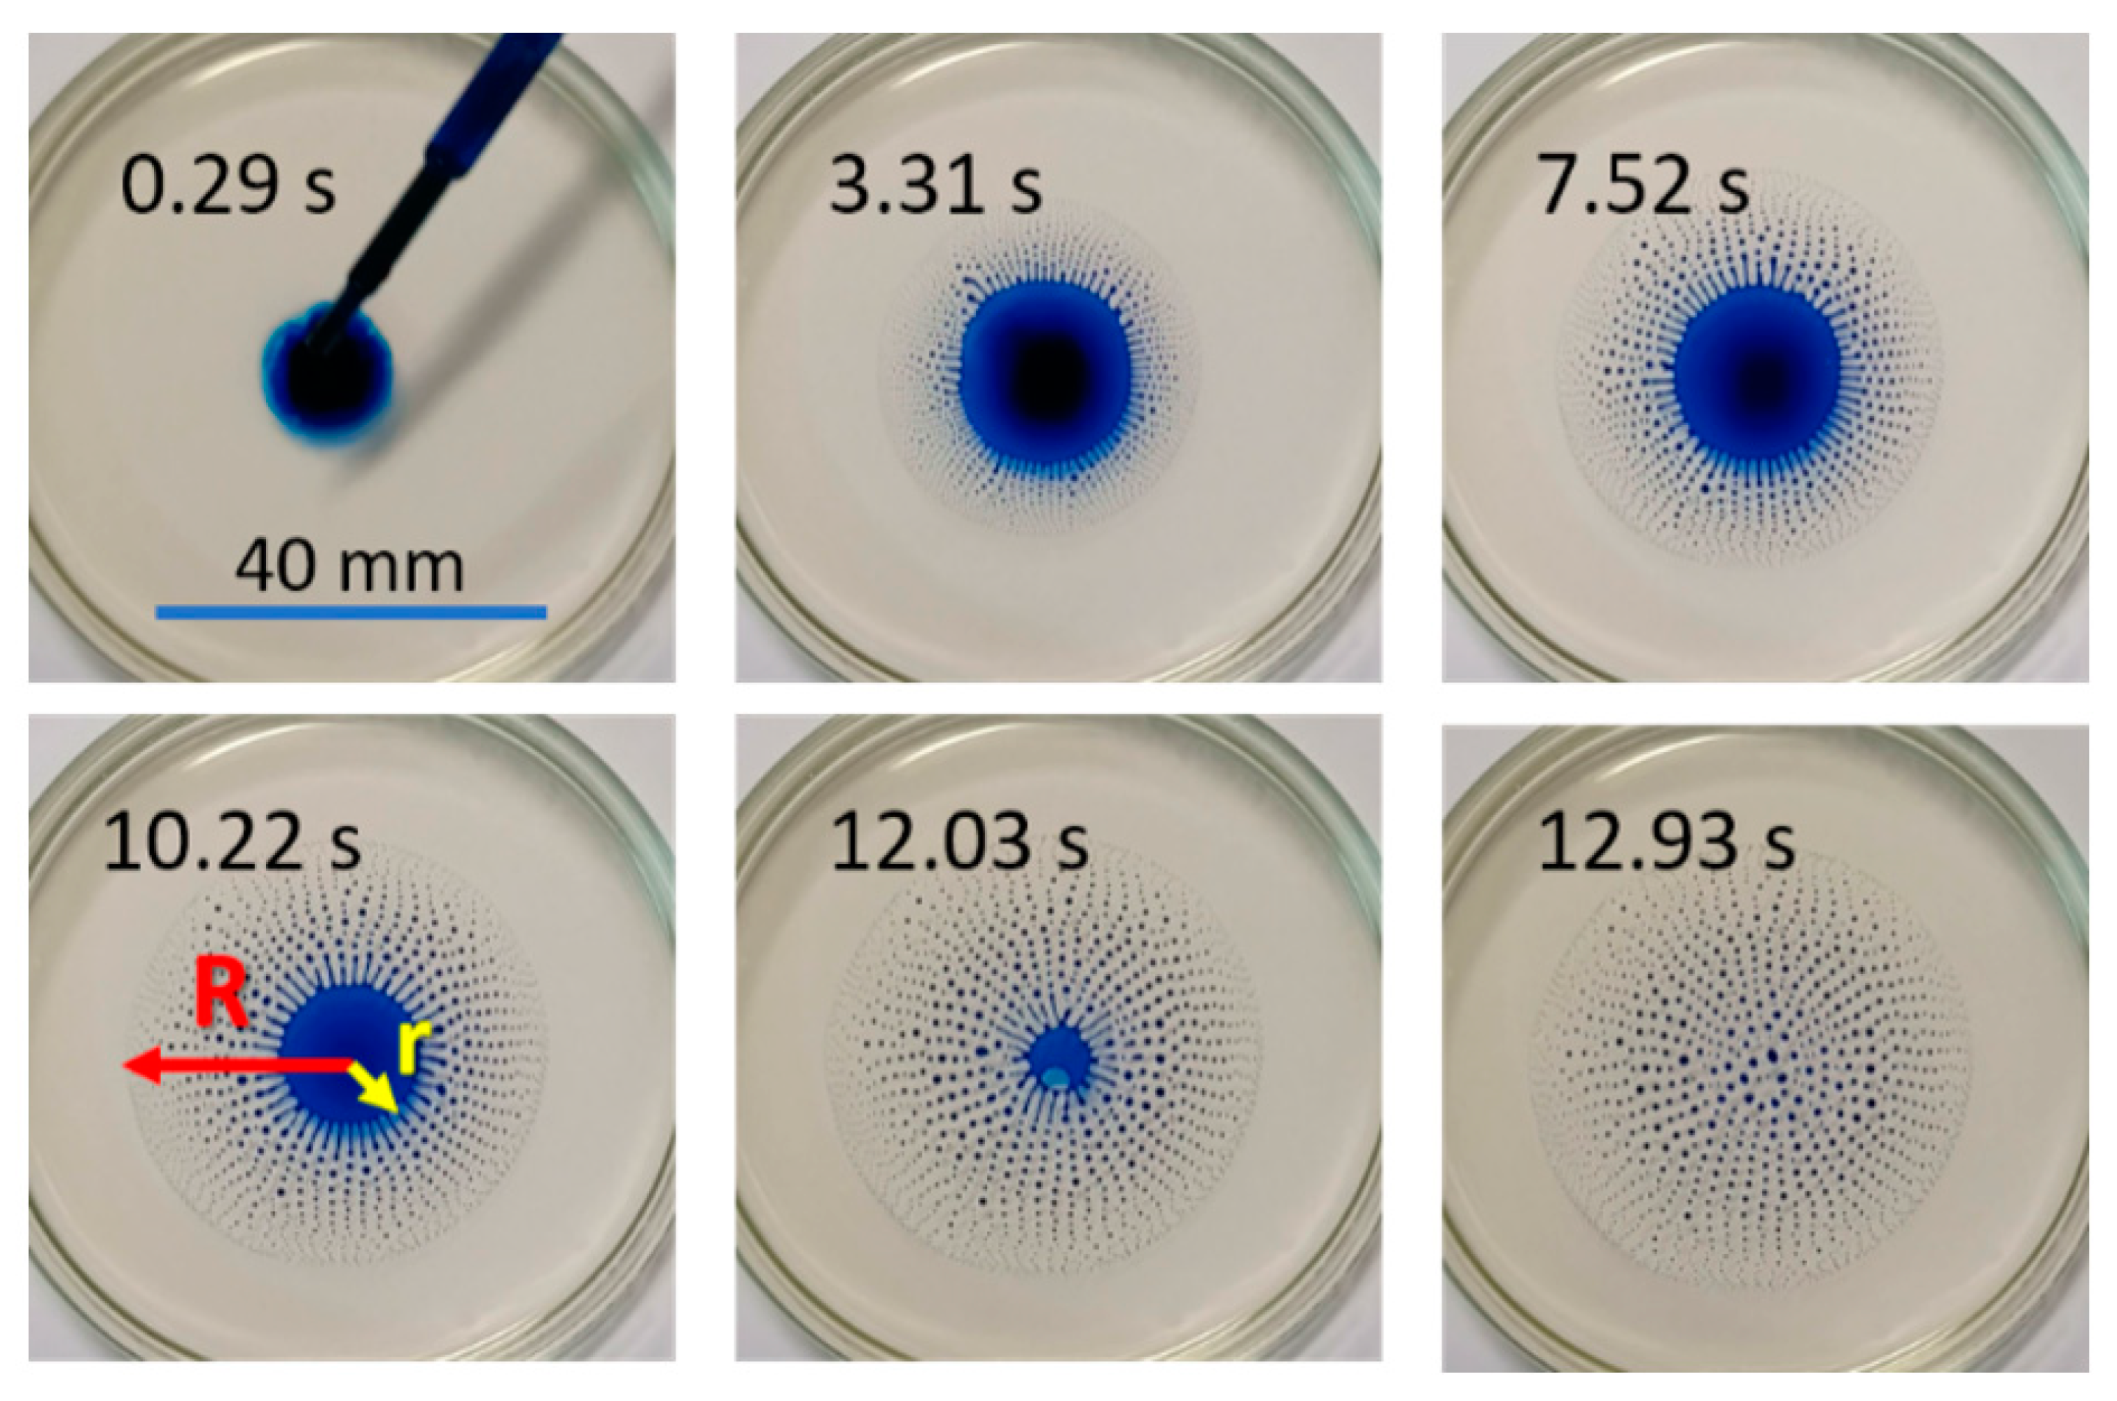
Fluids 08 00255 g001

3.1. Classic Marangoni Bursting Experiment
The exemplary Marangoni bursting phenomenon for
ϕ0 = 0.45, IPA/water with brilliant blue dye was recorded as a video movie and a few frames from it marked with a time
t (counted from the moment of contact of a binary mixture drop with oil phase) are shown in
Figure 1. As seen in
Figure 1, the mother drop of a volatile isopropanol and water solution with brilliant blue dye deposited at
t = 0 s spreads spontaneously over the rapeseed oil surface within a few seconds. The high wettability of the initial droplet composition is the necessary condition to observe the unusual fingering instability appearing at the expanding and next receding mother droplet edge. This instability leads to the spontaneous segmentation process of the solution into tens or hundreds of smaller (millimeter or sub-millimeter in size) daughter droplets that detach and escape from the mother droplet’s leading edge. Then, motile droplets move outside, and after approximately 13 s (for this particular composition), the process naturally slows down and droplet movement terminates. The conditions for the occurrence of this phenomenon can be summarized as follows: nonhomogeneous evaporation in a binary mixture, strong Marangoni stress, and a freely moving contact line on perfectly smooth surface [
43,
44,
45,
46].
The dynamics of Marangoni bursting is controlled by the continuous change in the surface tension of the alcohol/water mixture due to the evaporation of a more volatile component of the binary solution IPA/water. Isopropanol evaporates much faster than water—the IPA vapor pressure at 293 K is approximately 4.4 kPa, while that for water, at the same temperature, is only 2.34 kPa. IPA evaporation increases the surface tension of minute droplets, allowing their detachment at the ends of fingers, appearing at the mother drop edge and making them rounder, well separated, but also progressively smaller in size and weight during their movement toward the periphery area. Interestingly, after reaching the maximum distance
R (outer ring
R marked with red arrow in
Figure 1) from the center, droplets do not rest but spontaneously return at much slower speed than during the expanding phase (see
Figure 2). In this period, daughter droplets are slowly drifting over the oil surface, coalescing and tending to form a thin rim analogous to “coffee ring” effect observed for drying sessile droplet on a solid substrate [
45,
46,
47]. The residual brilliant blue amorphous remnants of non-volatile dye resting on the oil surface can be observed after both alcohol and water complete evaporation, i.e., at a time longer than ~600 s. After this time, no further movement is observed at the oil pool surface. In summary, the three stages of the phenomenon can be distinguished: (i) fast mother drop spreading due to wetting of the oil surface, (ii) fingering instability followed by emulsification of binary solution and (iii) slow shrinking evolution of daughter droplets followed by the formation of the rim, composed of the remnants of dissolved in binary solution substance, on the oil surface.
Based on the work of Keiser et al. [
30], Marangoni bursting is closely linked with the spreading coefficient
S, defined as
, where γs are respective interfacial tensions. Parameter
S must be positive to guarantee mother droplet spreading. This coefficient determines the energy per unit area of spreading and is counterbalanced by the viscous forces in the liquids. When the alcohol evaporation concentration of the binary mixture decreases below the critical fraction, and
ϕc ≈ 0.35, the spreading parameter reaches zero (
S = 0) and Marangoni bursting stops. Based on the definition of
S, it is obvious that even the subtle changes in the involved interfacial tensions γs may influence the condition of generation or annihilation of Marangoni bursting.
The briefly described here phenomenon is qualitatively understood; however, forces involved in self-propulsion and the final evolution of the system are difficult describe quantitatively due to the complex coupling of solutal and thermal Marangoni stresses and hydrodynamical effects. Another difficulty comes from the mother and daughter droplet mass reduction due to the non-constant evaporation rate of alcohol and water. In this process, dynamic Marangoni mixing also occurs both close to the mother drop edge (at fingering instability region) as well as in daughter droplets moving over the oil surface. The role of dye and its concentration added for visualization purposes also needs further investigation. All these facts underline the complexity of the studied system, making the analytical description and the simulation of the phenomenon extremely difficult. Therefore, we limited our work to discussing Marangoni bursting in its final stage of slow movement, where unusual shrinking of the daughter droplet area over the oil surface was observed.
3.2. Thermal Imaging of Marangoni Bursting in Dye-Free IPA/Water Binary Solution over Rapeseed Oil
We started our investigations by repeating the experiment of Keiser et al. [
30] for the IPA/water content (
ϕ0 = 0.45) but without any dye (cf.
Figure 2). Without the dye, the direct observation using a visible light color camera is difficult due to poor contrast. However, observation of Marangoni bursting by a thermal camera capable of monitoring surface temperature distribution is quite effective and carries information about the dynamics of temperature gradients arising during different stages of the process: spreading, wetting, emulsification, and finally water evaporation. This reference experiment differs from those performed with methyl blue dye added to the binary mixture prior to the Marangoni bursting observation.
In the sequence of photographs taken by a thermal camera, shown in
Figure 2, we can observe a few characteristic events. When the drop of the IPA/water binary mixture (
ϕ0 = 0.45) gently touches the oil surface, it starts to fast spread radially outwards over the surface (at 0.23 s) due to the strong wetting forces (small contact angle of the binary mixture with the oil surface). In this experiment, the initial temperature of the oil surface was approximately 23.5 °C. During binary mixture spreading, the initially small contact angle increases due to rapid evaporation of alcohol predominantly at the periphery of the droplet, which is marked by the blue color in
Figure 2, signifying temperature decrease to ~21 °C (refer to the color temperature scale in
Figure 2). Then, at some critical concentration difference, the spontaneous fingering instability appears at the edge of the initial/mother drop. Fingering instability starting at
t ≈ 8.3 s has led to the release of small daughter droplets. This process is hardly visible by the thermal camera in
Figure 2 due to the fact that the instability wavelength λ (the average distance between two neighboring fingers at the droplet edge circumference) is much smaller than that shown in
Figure 1 and comparable to the spatial resolution of the thermal camera with the wide view germanium lens. With time, more and more daughter droplets are released and move in a radial fashion until their propelling force vanishes. The receding of the mother drop is observed until the whole mother drop is divided into daughter ones that occurred at time
t ≈ 50–60 s. After this outstanding phenomenon seizes, the daughter drops remaining on the oil surface evaporate, approaching each other, coalescing and drifting, forming a ring-like shape. At longer times, daughter droplets are mainly composed of water. Then, they migrate, forming an outer ring of radius R (at
t ~ 90 s). This ring shrinks with a far smaller velocity than that observed in the initial expansion period. In the final stage (100–620 s), no alcohol is left in the droplets, and the system evolution is driven by water evaporation only, which is signified by the reddish–blue colors seen on the pool surface.
It has been experimentally confirmed that within 20–30 min, the ring disappears completely and under thermal camera view there are no more visible gradients of temperature. Based on the reference experimental findings shown in
Figure 2, we plot the dependence of the peripheric ring radius
R as a function of time and show it in
Figure 3. Spreading of droplets over clean flat surfaces often obeys a power law growth of radius in time [
41]:
with exponent
n = 0.75. We observed generally similar behavior (
Figure 3); however, the spreading exponent coefficient
n was estimated to be
n ≈ 0.256, i.e.,
. Interestingly, the process of shrinking of outer radius
R seems to obey the power law decay as well, and the shrinking exponent coefficient
n’ ≈ −0.356 was estimated for the studied system (see the inset to
Figure 3). We think that the fast alcohol evaporation causes this slowdown of peripheric ring expansion rate during Marangoni bursting over oil. This process induces, at the peripheric edge, thermal gradients resulting in immediate launching of counter flow of oil due to thermocapillary Marangoni stress that adds to pure viscous stress. Similar dependence
has been measured for the IPA/water binary mixture with
ϕ0 = 0.50 (see
Figure S5 of ESI) but the power low dependence
is different, we observed exponent
n = +0.3 during the expansion period and exponent
n’ = −0.3 during the contraction phase.
From the
R(
t) dependence presented in
Figure 3, we calculated the velocities
of the outer ring radius changes both in expansion and shrinkage periods and show them in
Figure 4. The dynamics of the process is highly nonlinear, with maximum velocity reaching 7 mm∙s
−1 at the beginning of spreading period and 0.1 to 0.003 mm∙s
−1 in the receding of daughter droplets area and the final stage of ring shrinking, respectively. The detailed values of velocity depend on the initial mass fraction
ϕ0 of the binary mixture and the oil properties. We postulate that the origin of the effect of slow movement and shrinking of daughter droplet area over the oil surface with time can be related to the thermocapillary Marangoni effect taking place on the oil surface but also in its volume due to momentum transfer. This supposition is validated by the observation of temperature gradients over the oil surface picked up by thermal camera until time ~600 s. Diddens et al. [
46] in their work also observed that after the complete evaporation of alcohol from a binary mixture, strong Marangoni flows are still present. The phenomenon of the inward mass migration in a drying water droplet on a solid surface has been observed and described by Weon and Je [
47], where the Marangoni effect reversed the coffee-ring effect.
3.3. Thermal Imaging Study of Marangoni Bursting in IPA/Water Binary Solution Containing Methyl Blue Dye over Rapeseed Oil
Before discussing the results of Marangoni bursting in IPA/water binary solution studied with thermal camera, we present in
Figure 5 the schematic view of the phenomenon, similar to that presented in [
30], but underlining the role of the thermocapillary Marangoni effects both in binary solution as well as in the oil pool.
In
Figure 5a, where the side view of the oil pool is schematically shown, the
R(
t) (outer ring) describes the radius of the spreading thin layer of a binary mixture alternatively carrying daughter droplets generated in the fingering instability process. A smaller radius
r(
t) denotes the edge extension of the mother drop from its center. The
jv symbol describes the evaporation rate of alcohol and water, Δ
T(
x,
y) =
Tsurface(
x,
y) −
Tambient(
x,
y) is the local temperature difference field over the oil surface, Δγ(
c) describes the local difference in binary solution concentration on the oil surface causing wetting spreading.
MaT denotes thermocapillary Marangoni flows in the oil phase (see the red arrows in
Figure 5a, Δ
F(
t) describes the net force resulting from all the forces acting at the surface,
hm is the thickness of the layer at the instability edge of the mother drop, and finally,
H is the thickness of the oil layer in the bath. The thickness of the oil layer cannot be too small; otherwise, Marangoni flows in the oil can be hampered. The red and blue horizontal arrows (
Figure 5a) describe the counter-propagating near-surface streams of fluid mass in the oil phase. In
Figure 5b, the simplified scheme of Marangoni bursting is shown as seen from the top; the white arrows inside the main droplet indicate the thermocapillary Marangoni flow in the binary mixture that causes the elongation of fingers outside the mother drop edge and promotes the droplet pinch-off outward the edge. It is clear from observations that instability wavelength
λ depends on time
λ(
t) due to temporal dependence of alcohol/water concentration caused by faster evaporation of alcohol close to the droplet edges where the layer of solution is very thin (
hm). In
Figure 5b, vectors of the speed of wetting
vw(
t) for expanding droplet edge and the velocity of retraction of the mother droplet edge
vr(
t) are also marked. Noticing the quite uniform temperature in between daughter droplets, we conclude that droplets are moving by sliding on a thin layer of the wetting binary mixture, at least in the initial phase of the phenomenon. By the nature of the recording infrared radiation, we can measure the temperature of the investigated objects with an accuracy of only ±2 K. However, we were able to distinguish local dynamic changes in temperature with the precision of ±0.1 K at a rate of 30 frames per second. Detailed observations have shown that the wetting-driven flows are accompanied by thermocapillary effects acting at all stages of the development of macroscopic flower-shaped patterns. In
Figure 6, we present the Marangoni bursting phenomenon seen by the thermal camera for the system with a binary mixture close to the critical IPA/water concentration
ϕ0 ≈
ϕc = 0.35 that should result in the highest value of fingering instability wavelength
λ.
The goal was to gain insight into the temperature distribution in a separate ligament and separate daughter droplet with satisfactory thermal and spatial resolution. The sequence of events presented in
Figure 6 shows that fingers are starting to be visible already at time
t = 1.287 s with 26 fingers at the circumference while at time
t = 4.686 s only 10 fingers can be identified. The area of deep-red color is assigned to the position of the wetting layer. The detachment of daughter droplets is not observed until time 2.28 s, and after this, the receding process of mother drop commences. Despite that, the large circular area with a clearly marked border has a lower temperature than the oil phase, suggesting a continuing evaporation process in this area. When the daughter droplet movement begins to be very slow, the droplets are seen as the separate centers of lower temperature circles floating over the uniform, a little warmer, thin evaporating layer of remnants of the initial solution (
Figure 6 photos taken at 9.9 s and ~16 s). The nonuniform temperature distribution is seen in the mother drop as well as in larger daughter ones.
A closer analysis of the droplet pinch-off process as seen by the thermal camera is presented in
Figure 7, where temperature changes are plotted against the distance along the chosen cut lines. The droplets forming at the finger ends have nonuniform temperature distribution across them, i.e., with the coldest area at their periphery (see
Figure 7). The maximum magnitude of the temperature difference between the oil phase (at the bottom of
Figure 7a) and the cold area at the finger periphery amounts to Δ
T = 3.7 K, while the maximum temperature difference between the oil phase and the mother drop center amounts to Δ
Tmax = 4.2 K. The largest temperature gradient, ∇
T ≈ 3.5 K∙mm
−1, was observed at the daughter droplet edge just before the moment of its release (see also
ESI Figure S1). Evidently, this proves that 2D thermocapillary Marangoni flows in the binary mixture are directed from the center toward mother droplet periphery. Similar temperature gradients were reported by Hasegawa and Manzaki [
43] and were postulated to drive the Marangoni stress.
Another cross-section (see white line in
Figure 7b shows a similar sharp temperature decrease at the finger end, with the precisely determined temperature change in Δ
T = −2.4 K resulting in a temperature gradient ∇
T ≈ 6 K∙mm
−1. Thermal imaging shows that thermocapillary effects are superimposed on the wetting-driven flows. The wetting phenomenon of binary solution over the oil phase induces a process similar to Plateau–Rayleigh instability [
48] known for the stream of falling water; however, gravity forces playing a role in Plateau–Rayleigh instability are replaced here by the forces tangential to the surface.
Then, at periodic locations at the mother droplet circumference, fluctuations in radial spreading led to the growth of fingers (shoots) of alcohol/water solution. The fingers are pushed outward and amplified by the Marangoni thermocapillary flows, as shown in
Figure 5b by white arrows with Ma label. The shoots are being elongated and then, by minimizing their surface energy due to Laplace pressure [
48], they spontaneously detach from the mother droplet, moving away, propelled by tangential wetting forces [
49,
50]. Ejection of subsequent droplets depletes the mother droplet volume, resulting in its inward retraction accompanied by further daughter droplet release. They, however, are moving at a much lower speed than during the initial expansion process. The temperature distribution along the chain of released daughter droplets is shown in
ESI Figure S2; the droplets are colder than the surrounding surface temperature by ~1.3 K on average.
We observed the Marangoni bursting phenomenon with a thermal camera systematically for the different initial compositions of the binary mixture:
ϕ0 = 0.35, 0.40, 0.45, 0.50, 0.55, 0.60 and 0.70 IPA/H
2O with methyl blue dye. Examples of these observations are attached in
ESI as Video S1 (
ϕ0 = 0.40),
Video S2 (
ϕ0 = 0.45),
Video S3 (
ϕ0 = 0.50),
Video S4 (
ϕ0 = 0.60) and
Video S5 (
ϕ0 = 0.70). For details of Marangoni kinetics in the expansion process for
ϕ0 = 0.70, refer to
Figure S3 and in the shrinking phase to
Figure S4 of ESI. With the increase in the initial content of alcohol in the binary mixture, the continuous decrease in fingering instability wavelength
λ was observed (from mm to μm range) according to the earlier reported findings [
31,
44]. The initial concentration of alcohol in the binary mixture influences the wetting speed and therefore the process is faster for higher alcohol content. The decrease in the outer ring
R(
t) as a function of time occurs for any of the studied systems. Interestingly, we have noticed that the shrinking of external ring
R(
t) is accompanied by the removal of daughter droplets from the central part that was built after the complete vanishing of the mother drop. The process of drifting of daughter droplets pushed both from the outside as well as from the inside has attracted our attention and needs understanding. This process naturally ends with the formation of a thin ring. The described phenomenon is shown well in
ESI Video S2 and is also shown in
Figure 8 in the form of a sequence of photographs. In
Figure 8, the process of the formation of a warmer region in the center of the initial deposition of the binary mixture drop is already seen at
t = 8.62 s (see the appearance of a reddish area). Later on, the daughter droplets move radially out of the center (
t = 43.03 s), forming finally a ring-like area of lower temperature.
The decrease in the outer ring radius and increase in the inner ring one finally leads to the formation of the thin cold ring, which stays at the same position until complete evaporation of water. The temperature difference between an oil surface with flowing daughter droplets and the area free of them results in the temperature gradient that drives the thermocapillary Marangoni effect in the oil phase. In the next subsection, we will model the flows in oil that forms the cold rings over the oil surface, as evidenced in
Figure 8.
3.4. Computer Fluid Dynamics Simulations of the Role of the Thermocapillary Marangoni Effect in Oil on Shrinking of the Outer Ring
The thermocapillary effect that accompanies the Marangoni bursting process is too complicated to be modeled; therefore, we simplify it to model the thermocapillary Marangoni effect due to the presence of static circular shape regions of lower temperature at the oil surface. For that purpose, we use the COMSOL Multiphysics 5.6 platform for performing Computer Fluid Dynamics simulations. We limited our simplified model to three cases (
Figure 9a) by the artificial deposition of the uniform surface temperature over the oil surface: (i) the full cold circle (observed at 8.6 s in
Figure 8); (ii) the cold ring (observed at 43 s in
Figure 8); and (iii) the cold rim (observed at 600 s, not shown in
Figure 8).
Initially, we assumed that the three areas have the same temperature that is lower than room temperature (295.3 K) by Δ
T = −5 K and is stable at least during the period of a few seconds. This is supported by the result shown in
ESI (Figure S1), where the measured difference in temperature reached as much as |7.5| K. Under such simplifications we solved in 3D the Navier–Stokes equations in laminar approximation coupled with heat transport equations. In
Figure 9b,c, we show the results of simulations of u
x and u
z fluid flow velocity components at a line positioned slightly below the surface of an oil along the
x-axis. It is obvious that flows in oil parallel to the surface are directed toward colder areas where the surface tension is higher, but it is not as evident that there is also a flow directed upward, i.e., along the
z-axis (see
Figure 9c). The response to the temperature gradient appearing at the oil surface is very fast; after only 0.05 s, the lateral flow velocity at the surface reaches value |u
x| = 25 mm∙s
−1 and the vertical component |u
z| = 7 mm∙s
−1. This is caused by the large thermal Marangoni shear stress:
assumed in our simplified model. By viscous momentum transfer, these fluid movements are generated also in the bulk of an oil pool.
In
Figure 10, we show simulations which allow us to understand the mechanism of the slow shrinking of daughter droplets area. It is represented by a wide, colder ring similar to that observed in
Figure 8 at
t = 43 s. The simulation experiment geometry with cut line positioned along the
x-axis slightly below the oil surface, surface temperature and fluid velocity fields are shown as a function of time in the range (0 to 4 s). Results of simulations qualitatively explain that the Marangoni fluid flows due to temperature gradients at the oil surface are responsible for the shrinking of the cold ring area of daughter droplets. They are acting from outside as well as from inside the ring as shown in
Figure 10c. Fluid velocities directed outward the ring center are slightly smaller (<2 mm∙s
−1) than those acting toward the center. This explains the reason for slow ring shrinking arising from the competition of two counter-propagating fluid flows. Therefore, the movement of daughter droplets is very slow as compared to the initial phase in which they are created. Note, that almost instantly appearing Marangoni flows in oil cause temperature changes due to convective heat transport in the oil volume (see
Figure 10b, where the multiple lines show the temperature evolution from the initial one at t = 0 s designed by the blue line). In
Figure 10d, we can see that the fluid velocity component along the
z-axis u
z causes the mixing of oil in the bulk. The warmer oil from near the dish’s walls moves down, while the volume of oil inside the ring moves up. The mixing reduces temperature gradients and causes the slowdown of the whole movement. The temperature gradients of cold liquid at the surface (evenly distributed) influence the oil bulk movements that tend to reduce the temperature gradients and finally form a smooth cold ring. Simulations performed for a narrow cold ring adequate to the final stage of shrinking are shown in
ESI (Figure S6).
The high-temperature difference Δ
T = −5 K used in the preliminary simulations presented in
Figure 9 and
Figure 10 is not representative of the final stage of the process. Therefore, as proof of a principle, we performed full 3D simulations assuming a more realistic surface temperature decrease of only Δ
T = −1.5 K (
Figure 11). We considered the case of daughter droplet ring-shaped area under the assumption that it is uniform and stable in time (at least within 10 s), again for the case observed in
Figure 8 at
t = 43 s. The geometry of simulation and heat exchange between the surface of oil and its bulk are shown in
Figure 11a,b. In
Figure 11c,d, instead of showing magnitudes of the velocities of fluid flows, we draw the vectors and streams, respectively. Representing velocity vectors are shown as red arrows centered in the midpoint. They show that the flow is directed from outside toward the center, but arrows perpendicular to the surface show that there is a flow of warmer oil from the bottom of a Petri dish to the surface. In
Figure 11d, one can notice that closed loops of oil flows are present in the whole oil bulk. We may conclude that the two key fluid velocities (tangential and perpendicular to the surface) that are generated in the oil surface are responsible for gathering the daughter drops into the ring and then its shrinkage.
Simulations also show that the velocities of temperature gradient-driven Marangoni flows in rapeseed oil could be comparable to the wetting expansion velocities of the binary solution, i.e., approximately 32 mm·s
−1. These Marangoni flows have opposite directions to mother droplet movement during the bursting process and, therefore, must slow down the wetting propagation of the binary mixture over the liquid surface. We do not expect good matching between experiments and simulations due to the simplicity of the latter. However, we can estimate the influence of the thermocapillary Marangoni effect based on measured temperature gradients. Marangoni number describes the ratio between the advective transport rate of heat and its diffusive transport rate. By definition:
where
is the temperature coefficient of surface tension of substrate liquid, Δ
T is the surface temperature difference along a distance L parallel to the surface at which the surface tension difference
has been built,
μ is the dynamic viscosity, and α
T is the thermal diffusivity of the liquid. By equating the thermocapillary stress gradient
to the viscous stress
, where
u is the speed of Marangoni flow, one obtains the speed of flow:
. Assuming
= 1.5 K from the experiment and
= −0.0000758 Nm
−1K
−1 for rapeseed oil the calculated surface tension difference amounts to
= 1.137 × 10
−4 Nm
−1. Then,
0.175 ms
−1 where
μ = 6.5 × 10
−4 Pa·s. Taking
L = 1 mm, the theoretical value of Marangoni number amounts to
Ma = 1796
1800. The observed flow velocities of the outer ring edge movement are generally much smaller. However, in the case of Marangoni bursting they always result from the two competing counter propagating flows.
Thus, we can conclude that the thermocapillary Marangoni effect is important in Marangoni bursting from the very first moment of droplet deposition on the oil substrate until the formation of non-movable ring at the end of the phenomenon. The Marangoni flows that are dependent on temperature gradients play an important role in fingering process at the droplet edge. When the oil layer thickness becomes too thin, the loops of liquid flow have difficulty to build up because of hampering the fluid speed at the bottom of the Petri dish (note that in the simulations we used no-slip conditions).